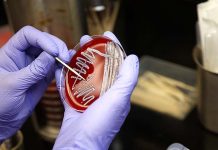
Investigating diseases affecting poultry production
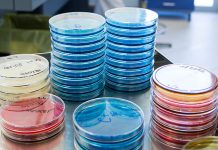
Major histocompatibility complex and genetic resistance to Infectious Bronchitis Virus
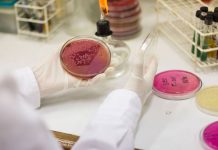
Salmonella, creating the most undesirable environment
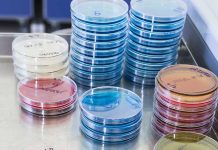
Vaccination of turkey breeders to control Salmonella

Investigating diseases affecting poultry production
Severe diseases such as highly pathogenic avian influenza and velogenic Newcastle disease are still a concern for poultry producers and government agencies alike. Companies...
Quality Control Audits of killed vaccination
Vaccination programs for breeders and egg layers include procedures with inactivated vaccines. Killed (inactivated) vaccines are used to prevent disease in the vaccinated bird...
Gut health
Gut health and the efficient conversion of feed into its basic components for optimal nutrient absorption is vital for both commercial and turkey breeder...
Towards practical methods for assessing ILTV vaccine take
In response to ILTV outbreaks, live vaccines are typically administered at 7-14 days of age in drinking water via nipple drinkers which may not...
On-farm control of campylobacter
Campylobacteriosis, primarily caused by the consumption of contaminated chicken products, accounts for the majority of food poisoning cases in Europe and many other developed...
Effect of difference doses of Newcastle disease vaccine immunization on broilers
Influence on growth performance, plasma variables and immune response
As a member of the Paramyxoviridae group, Newcastle disease virus (NDV) is the key causative agent...
Microbiota studies in poultry
The microbial populations that inhabit the gastrointestinal tract (GIT) of birds play an important role in the establishment and maintenance of a healthy gut....
The manureshed concept: a solution to poultry litter nutrient recycling?
Surface waters in the United States are regularly assessed as a part of the Clean Water Act to determine whether the water quality protects...
How a single Avian Influenza protein can increase period of infection
New research led by scientists at The Pirbright Institute has shown how an Avian Infuenza a virus protein, called PB1-F2, is able to shut...
NWO OTP grant awarded to WUR project aimed at head start for day-old chicks
The immune system of a chicken starts in the egg. Validated tools to assess how incubation conditions influence immune development are lacking. A new...
New avian flu outbreak detected on a farm in the Urgell region (Catalonia)
The Government of Catalonia has confirmed the detection of a new case of avian influenza on a poultry farm located within the surveillance radius...
Turkey reoviral arthritis update
Avian reoviruses (ARVs) belong to the genus orthoreovirus in the family Reoviridae. They are nonenveloped, double-stranded RNA viruses that are ubiquitous in domestic poultry...
How Necrotic Enteritis affects animal’ welfare and performance
Necrotic Enteritis (NE) affected flocks have poor enteric health and nutrient digestibility leading to decreased performance and increased excretion of nutrients.
Evidence suggests that...
Monitoring of IBV circulation and prevalence
Infectious bronchitis (IB) is one of the most common viral diseases in chicken production worldwide and IB virus (IBV) is considered the most contagious...
Gut health and Coccidiosis
In poultry, gut health is fundamental and the gastrointestinal tract accounts for twenty percent of the energy expenditure of the whole body. This energy...
UK Veterinary Vaccinology Network
Veterinary researchers from around the world came together at this year’s joint UK & International Veterinary Vaccinology Network Conference on the 9-10 January 2019...
Should the US rethink its avian influenza policy?
➤ Tom Tabler, Professor and Extension Poultry Specialist, Department of Animal Science, University of Tennessee Institute of Agriculture
➤ Tanner Thornton, Graduate Research Assistant, Department...
Use of injection syringes in the animal production industry
Animal health is an important factor to consider, as any disease outbreak can potentially have drastic economical consequences. For this reason, planning and preparing...
Pulsed ultraviolet light processing of eggs
In recent years, pulsed ultraviolet light has been shown to reduce microbial pathogens on the surface of shell eggs, crucial for maintaining good chick...
Water disinfection in poultry farms: a low-cost practice with high impact
Water is often overlooked as a source of disease risk in poultry farming. Yet, when it comes to biosecurity, drinking water is one of...
Macroscopic lesion scoring correlates with gut morphology changes in a newly developed dysbacteriosis model
Conventional broilers often experience intestinal problems between 20 and 30 days of age, caused by a microbial imbalance in the gut, which is referred...
How do coccidiosis challenges influence lipid digestibility and energy utilisation?
Coccidiosis continues to be one of the most pervasive and economically detrimental diseases in commercial poultry production. Controlling this enteric disease is an even...
Chlamydia spp. detected in poultry in Piedmont, Italy
Chlamydia spp. are agents of re-emerging infections in poultry worldwide and deserve attention from a public health perspective due to the well-known zoonotic nature...
Pathogenesis of egg infections by Salmonella – First Part
Salmonella is an invasive bacterial genus and colonizes the gut of chickens, and systemically spreads to internal organs, including the reproductive tract, potentially leading...
Obtaining the most benefit from an anticoccidial sensitivity test
The poultry industry has been using the same anticoccidial drugs for the prevention of coccidiosis for several decades. The last approval of a new...
A new poultry research center at the University of Bristol
A state-of-the art poultry research centre offering specialist, industry-focused research into both laying hen and broiler health, welfare, behavior and productivity has recently been...
Research provides Insight on colonization of broilers by Salmonella
USPOULTRY and the USPOULTRY Foundation announce the completion of a funded research project at Auburn University in Auburn, Alabama, in which researchers were able...
How to guard your hatchery against biosecurity threats
Biosecurity, by simple definition, is a set of procedures undertaken to limit the spread of infectious pathogens to a susceptible population. It is, however,...
Use of comparative genomics to identify vaccine candidates for Campylobacter Jejuni
Interventions to control and reduce the incidence of Campylobacter jejuni colonization in poultry is important in order to reduce the burden of foodborne illness in humans....
The effects of diet and epigenetic alterations on the gut microbiome, inflammation and poultry...
The gut microbiota is a fundamental force influencing diverse aspects of avian physiology. Microbiome studies are at a critical juncture and facing a challenging...
Research shows nutritional effects of Coccidiosis vaccination
A funded research project on Coccidiosis was completed at the University of Arkansas in Fayetteville, Arkansas, that shows the nutritional effects of coccidiosis vaccination.
Project...
Gut health, intestinal innate immunity and performance
Gut health is a very important determinant for health and performance in particular in production animals. The intestinal innate immune system is pivotal in...
Frontiers in human and veterinary antibody discovery
The Pirbright Institute hosted the inaugural Comparative Veterinary Immunology Group (CVIG) meeting Frontiers in Human and Veterinary Antibody discovery on 26 and 27 November,...
Analysis of anti-Ascaridia galli antibody levels in egg yolk to detect parasite infection in...
In recent years, in response to consumer concerns regarding welfare of birds, there has been a move from caged to free-range production systems. This...
Biological control of Salmonella in the poultry industry: a European perspective
Salmonella remains one of the most important foodborne bacterial pathogens worldwide, and is frequently linked with the consumption of contaminated poultry meat and eggs....
Feeding the commercial turkey
Choosing the most effective feeding programme has never been more important given the unpredictability of the raw material market and lack of consistent supply...
Protozoal management in turkeys
The two turkey protozoa that cause significant animal welfare and economic distress include various Eimeria species of coccidia and Histomonas meleagridis. For coccidia, oral...
Concurrent infection of Histomonas meleagridis and Eimeria meleagridis in a turkey flock
Blackhead disease (histomoniasis) in turkeys is one of the protozoan diseases sporadically documented in commercial turkey production facilities. Histomoniasis may induce mild, moderate, or...
Enumeration of Ascaridia Galli eggs in chicken excreta
Excreta counting techniques in eggs can provide valuable information for assessing flock infection levels, selecting nematode resistant chicken breeds and for determining anthelmintic efficacy.
Although...
Research shows how Infectious Laryngotracheitis can spread from vaccinated flocks
The research on how Infectious Laryngotracheitis can spread from vaccinated flocks was made possible in part by an endowing Foundation gift from Claxton Poultry...
Major histocompatibility complex and genetic resistance to Infectious Bronchitis Virus
Infectious bronchitis virus (IBV) is an endemic disease of chickens responsible for considerable economic losses to the poultry industry worldwide. IBV replication leads to...
Collaborative regulatory approach can reduce antibiotic use in animal production
As global concern about the human health threat posed by antimicrobial resistance continues rises, governments continue to introduce legislation to curb antibiotic use in...
The relationship between sperm function and diet – Toms are what they eat
It is well known that cryopreserved semen could be used to regenerate commercial or research poultry lines; however, fertility rates from poultry semen frozen...
Case report: histomoniasis in broiler breeder pullets
Histomoniasis, commonly known as blackhead disease, is caused by an anerobic protozoan parasite, Histomonas meleagridis. Histomoniasis affects all gallinaceous birds and turkeys are the...
Salmonella, creating the most undesirable environment
Background
Salmonella non-typhoidal is among the top foodborne bacteria that cause illness within the United States annually.With 1.4 million illness (11% of foodborne bacteria), 19,336...
Footpad dermatitis in market turkey hens. Bird density and bedding material relationships
Lameness
and poor footpad condition can be major issues for meat-type poultry resulting
in their decreased well-being and decreased productivity. A large body of
research exists for...
Infectious Coryza in vaccinated layers: are vaccines failing to protect?
During 2017 and 2018 Infectious Coryza was detected in several commercial vaccinated egg layer flocks in California. The Avibacterium paragallinarum strains isolated from infected...
The Omics revolution – Implications for animal production
What does Omics mean?
Omics is a term that refers to the recently developed high throughput technologies that include genomics, functional genomics (transcriptomics), proteomics, and...
Chicken study probes resistance to food bug
Receiving gut microbes from resistant chickens does not lessen chickens’ susceptibility to bacterium that causes food poisoning.
Susceptible chickens became even more susceptible to Campylobacter,...
Nutritional strategies against pathogens in poultry
Salmonella Enteritidis and Campylobacter jejuni are the two major foodborne pathogens transmitted through poultry products. Since chickens are the reservoir hosts of these pathogens,...
How Marek’s disease may directly affect the chicken immune system
Marek’s disease virus (MDV) causes disease in chickens and is estimated to cost the global poultry industry up to US $2 billion each year.
In...
Continuous monitoring and control of mycoplasma for sustainable poultry production
Mycoplasma gallisepticum (MG) and Mycoplasma synoviae (MS) remain persistent pathogens in poultry, causing respiratory disorders, synovitis, uneven growth, and reduced egg production. Determining the...
Influenza antibodies made by Pirbright reduce disease in chickens
Scientists at The Pirbright Institute have engineered synthetic antibody
molecules that can be administered to poultry to reduce the symptoms of Influenza, as well as...
Ability to detect Salmonella vs. Salmonella-Free in poultry processing
Poultry are sampled often for Salmonella during growout on the farm and throughout the processing plant. While on farm sampling is not currently a...
Cochlosoma anatis in turkeys
A funded research project at North Carolina State University in Raleigh, N.C. evaluated the pathogenicity of Cochlosoma anatis. The research was made possible in...
Holistic view of intestinal health in poultry
Intestinal health is necessary to maintain efficient and sustainable gastrointestinal tract (GIT) physiology. The GIT has digestive, absorptive, metabolic, immunological and endocrinological functions.
This means...
World Veterinary Day – celebrating the value of vaccination
The theme of this year’s World Veterinary Day – celebrated April, 27th – was Value of Vaccination. To celebrate it, some of the vaccinology...
Researchers develop method for making new types of vaccines
USPOULTRY and the USPOULTRY Foundation announce the completion of a funded research project at the U.S. National Poultry Research Center, Southeast Poultry Research Laboratory in Athens,...
Novel Approach Improves Poultry Welfare by Reducing Stress on Chickens
MSD Animal Health (known as Merck Animal Health within the United States and Canada) recently announced the launch of EXZOLT® (fluralaner), the first systemic...
Research Rules Out Possible Kinky Back Prevention
USPOULTRY and the USPOULTRY Foundation announce the completion of a funded research project at North Carolina State University in Raleigh, N.C., in which researchers...
Research examines novel next generation sequencing techniques
USPOULTRY and the USPOULTRY Foundation announce the completion of a funded research project at the University of Georgia in Athens, Georgia, in which researchers...
When the gut rebels: the challenge of chronic inflammation in laying hens
In the poultry industry, intestinal health is a cornerstone for achieving high production yields, feed efficiency, and disease resistance. One of the issues that...
Blackhead disease: development of molecular tests and an in vitro assay to identify reservoirs...
This research project developed diagnostic assays needed for advancing the understanding of blackhead disease. The article shows clearly how the disease most likely spreads...
Histopathological evaluation of Histomonas meleagridis on ceca and the bursa of Fabricius in turkeys
Histomoniasis is caused by Histomonas meleagridis, a flagellated protozoan parasite. It causes systemic infection in turkeys and induces characteristic lesions in ceca and liver....
Transcriptomic modifications caused by subclinical necrotic enteritis in broiler chickens
Phasing out of in-feed antibiotics in the poultry industry has caused necrotic enteritis (NE) to become a primary concern in commercial poultry production in...
Vaccination of turkey breeders to control Salmonella
Salmonella continues to be a top food safety concern for the turkey industry, the USDA, and the consumer. Salmonella bacteria are the most frequently...
A multidisciplinary research approach on Avian Influenza in Italy
The Avian Influenza epidemic of 2016-2017 had been the largest in Europe in more than 10 years. The circulating virus was a Highly Pathogenic...
Testing day-old poults
When poults are received at a farm from the hatchery they should be good quality poults; namely, free from physical defects, actively looking for...
Comparing two ELISA kits
Here a comparison of two ELISA kits as been made to assess their efficicacy.
Recombinant turkey herpesvirus vaccines (rHVT) are being widely used for...
Avian influenza diagnostics in foxes provide valuable addition to mammal surveillance
Research by Wageningen Bioveterinary Research (WBVR) and the Dutch Wildlife Health Centre (DWHC) shows that foxes in the province of Friesland can become infected...
Practical guide for evaluating day-old chick quality: key standards and health monitoring
Evaluating the quality of day-old chicks (DOC) is crucial for successful poultry production. This practical guide outlines the key physical indicators, health factors, and...
The declining trend of salmonellosis cases in the EU has levelled off
Cases of Salmonella Enteritidis acquired in the EU have increased in humans by 3% since 2014 says the report, which is compiled by the...
Infectious bronchitis virus (IBV) vaccines produced in eggs have unpredictable mutations
Scientists at The Pirbright Institute have shown that infectious bronchitis virus (IBV) vaccines produced in eggs have unpredictable mutations which may be prone to...
Wooden Breast Disease
The emergence of Wooden Breast Disease in commercial broiler chickens has been associated with significant economic loss in the poultry industry resulting from severe...
Microbiological consequences of different housing systems for laying hens, with particular reference to Salmonella...
A significant proportion of human illnesses caused by Salmonella are linked to the consumption of contaminated eggs. In response, substantial government and private industry...
The role of feed additives in the protozoal diseases in poultry
Coccidiosis and histomoniasis are economically significant diseases in chickens and turkeys. Management, vaccination and medication are key tools in the control of these diseases...
Protecting poultry from Avian Influenza
The Avian Influenza season is upon us, but how much do you know about Avian Influenza? Do you know how to protect the birds...
Update on Infectious Bronchitis in the United States
Infectious bronchitis infections continued to increase this year in the Ontario broiler, broiler breeder and layer sectors.
Infectious bronchitis virus (IBV) can be spread by...
Engineering vaccines for multiple strains of IBV
In new work funded by a Biotechnology and Biological Sciences Research Council (BBSRC) researchers at The Pirbright Institute and The Roslin Institute have published...
A diagnostic laboratory perspective for pathogen detection
Detection of infectious diseases can generally be broken down into laboratory detection of the pathogen or detection of the immune response to the pathogen....